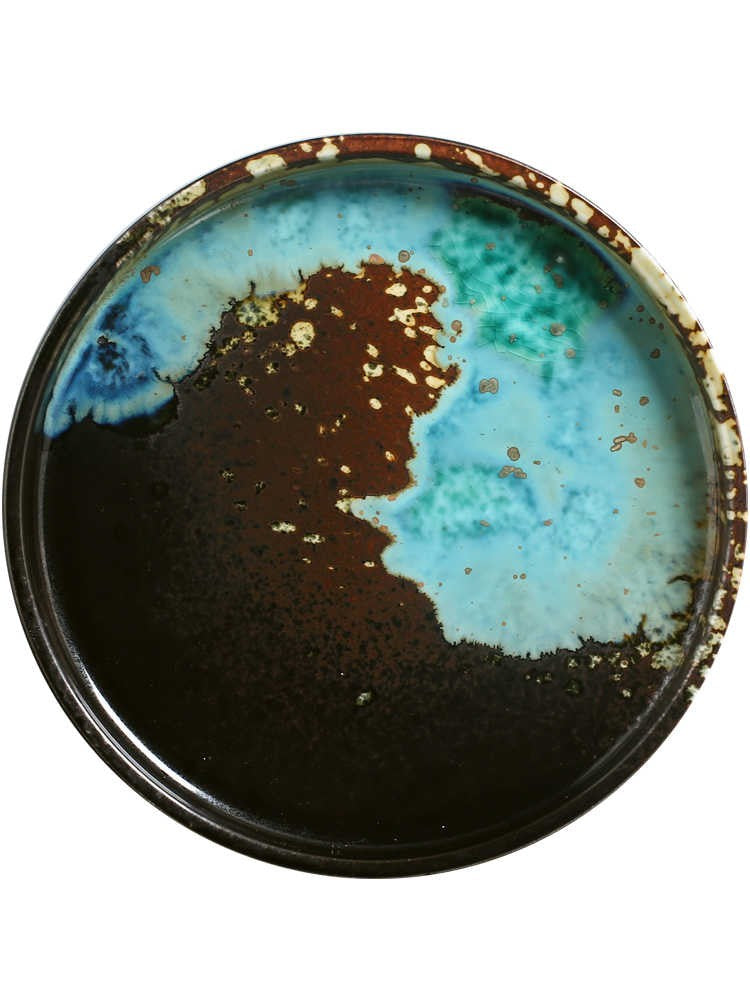
solstice-handcrafted-fruit-plate-01_e20de0e7-783d-4791-8ddb-e6f9c9de7147.jpg

Crafted for the Table, Designed for Living
Kalyvix offers thoughtfully crafted ceramic dinnerware designed to enhance everyday dining and special moments alike. Our collections combine timeless aesthetics, functional design, and dependable quality. We are committed to delivering beautiful, food-safe tableware with transparent policies and reliable service. At Kalyvix, every piece is made to feel at home on your table.